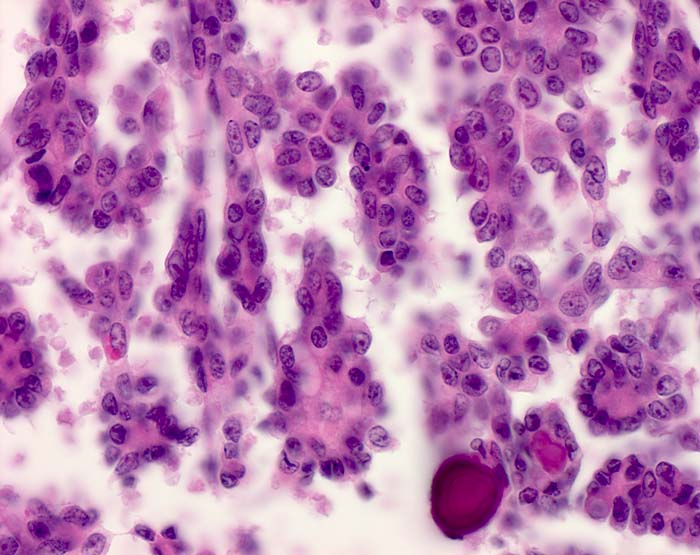

PathoPic – image database / PathoPic ID 7990 - Invasives mikropapilläres seröses Ovarialkarzinom
de
Diagnose
Invasives mikropapilläres seröses Ovarialkarzinom
Diagnose Gruppe
maligner Tumor
Topographie
Ovar
Topographie Gruppe
Genitalorgane, weiblich
Beschreibung
Dünne Mikropapillen. Die zytologischen Atypien sind geringer ausgeprägt als beim serös papillären Ovarialkarzinom. Psammomkörper.
Zusatzbefund
Stadium pT3c
Klinik
12cm grosser zystischer Ovarialtumor
Kommentar
Am J Surg Pathol. 2003 Jun;27(6):725-36.
Noninvasive and invasive micropapillary (low-grade) serous carcinoma of the ovary: a clinicopathologic analysis of 135 cases.
Smith Sehdev AE, Sehdev PS, Kurman RJ.
Noninvasive and invasive micropapillary (low-grade) serous carcinoma of the ovary: a clinicopathologic analysis of 135 cases.
Smith Sehdev AE, Sehdev PS, Kurman RJ.
Bilder Typ
Histologie
Vergrösserung
400
Alter
37
Geschlecht
unbekannt
Datum
Ersteintrag: 25.08.2004
Update: 10.08.2010